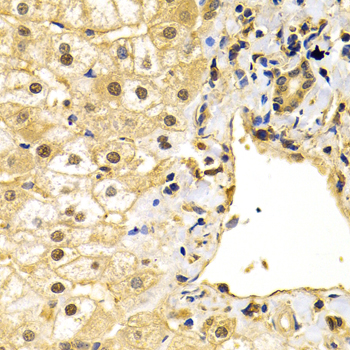

For quotations, please use our online quotation form, and you may also contact us by
service@kendallscientific.com
+1-888.733.6849 (Toll-free)
+1-617.299.7367 (Int’l))
+1-888.733.6849
Our customer service representatives are available 24 hours, Monday through Friday to assist you.| Reactivity | Human Mouse Rat |
| Tested applications | WB IHC IF IP |
| Recommended Dilution | WB 1:500 - 1:2000 IHC 1:50 - 1:100 IF 1:50 - 1:100 IP 1:20 - 1:50 |
| Calculated MW | 71kDa |
| Observed MW | Refer to Figures |
| Immunogen | A synthetic peptide of human VCP |
| Storage Buffer | Store at -20℃. Avoid freeze / thaw cycles. Buffer: PBS with 0.02% sodium azide, 50% glycerol, pH7.3. |
| Concentration | b |
| Synonym | VCP;IBMPFD;MGC131997;MGC148092;MGC8560;TERA;p97; |

Western blot analysis of extracts of various cell lines, using VCP antibody.

Immunohistochemistry of paraffin-embedded human gastric cancer tissue using VCP antibody.
Immunohistochemistry of paraffin-embedded human liver injury using VCP antibody at dilution of 1:200 (40x lens).

Immunohistochemistry of paraffin-embedded rat heart using VCP antibody at dilution of 1:200 (40x lens).

Immunohistochemistry of paraffin-embedded human esophagus using VCP antibody at dilution of 1:200 (40x lens).

Immunofluorescence analysis of A549 cell using VCP antibody. Blue: DAPI for nuclear staining.

Immunofluorescence analysis of GFP-RNF168 transgenic U2OS cell using VCP antibody.Green:GFP-RNF168 fusion protein expression for DNA damage marker.Blue:DAPI for nuclear staining.RNF168(GFP) can be used to mark cells damaged by UV-A laser for they always gather around DNA damage region.
Valosin-containing protein (VCP) is a highly conserved and abundant 97 kDa protein that belongs to the AAA (ATPase associated with a variety of cellular activities) family of proteins. VCP assembles as a homo-hexamer, forming a ring with a channel at its center (1,2,3). VCP homo-hexamers associate with a variety of protein cofactors to form many distinct protein complexes, which act as chaperones to unfold proteins and transport them to specific cellular compartments or to the proteosome (4). These protein complexes participate in many cellular functions, including vesicle transport and fusion, fragmentation and reassembly of the golgi stacks during mitosis, nuclear envelope formation and spindle disassembly following mitosis, cell cycle regulation, DNA damage repair, apoptosis, B- and T-cell activation, NF-κB-mediated transcriptional regulation, endoplasmic reticulum (ER)-associated degradation and protein degradation (4). VCP appears to localize mainly to the endoplasmic reticulum; however, tyrosine phosphorylation is associated with relocalization to the centrosome during mitosis (5).
N/A